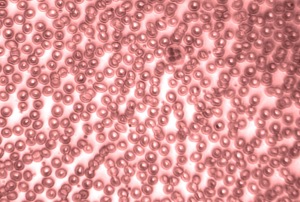
bloodok

For most patients with Pyruvate Kinase Deficiency, the disease manifests itself clearly from the moment the patient is born: the baby has jaundice, seems very weak, has a low hemoglobin,…which can lead to an early diagnosis of the disease. But for some patients, it takes months, sometimes even years to have the final diagnosis of Pyruvate Kinase Deficiency.
“I wasn’t the first in the family with this disorder, my sister was born with Pyruvate Kinase Deficiency two years earlier. So when I was born, my parents and the doctors knew why I looked like a beautiful yellow baby girl.”
Woman 40, The Netherlands
Physical exam
Symptoms like fatigue, shortness of breath and palor can be the first sign the patient is anemic. When the patient also has jaundice and dark urine, the doctors will probably suspect the anemia is due to a higher destruction of the red blood cells (also called hemolysis) and will do a blood test to confirm this.
Blood test
A complete blood test (also called Complete Blood Count or CBC) will give some valuable information to the physicians. People with Pyruvate Kinase Deficiency usually have low hemoglobin levels due to the early destruction of the red blood cells, which also leads to high billirubin levels (a waste product of red blood cells). Because the body compensates for this destruction by producing more red blood cells, there will be a higher rate of young, immature red blood cells (also called reticulocytes).
These changed levels in the blood analysis are very typical for hemolytic anemia. But of course, there are several kinds of hemolytic anemia, which all have a different cause (for example: thalassemia, sickle cell anemia, G6PD deficiency,…).
Blood smear
When a blood test shows abnormal results, a blood smear is often used to examine the different types of blood cells. For the test, a drop of blood is spread onto a glass slide and then examined using a microscope.
The morphology of the red blood cells in the blood smear can give some crucial information about the cause of the hemolysis. In some types of hemolytic anemia, the blood smear is enough to make a diagnosis because the red blood cells have such a particular shape. This is the case with Sickle cell anemia, which is easily recognized by the sickle formed red blood cells.
On the left image you can see a blood smear of a healthy person. The red blood cells clearly have this particular biconcave shape. The image on the right comes from a patient with Pyruvate Kinase Deficiency. The red blood cells don’t have this perfect biconcave shape. The dark, irregular cells are in fact reticulocytes, young immature red blood cells.

Enzyme activity
Through the blood smear, the physicians will probably have excluded other types of anemia such as sickle cell anemia. A presumption of Pyruvate Kinase Deficiency can then be confirmed through a blood test measuring the enzyme activity rate of the pyruvate kinase enzyme. Since pyruvate kinase deficiency is caused by a lack of the pyruvate kinase enzyme, a lower activity rate can confirm the diagnosis.
Genetic diagnosis
The best way to confirm the diagnosis of Pyruvate Kinase Deficiency is by genetic testing. The scientific literature reports more than 200 different mutations causing PKD. All these mutations affect one single gene (the PKLR gene). This gene codes for a protein called pyruvate kinase. In Pyruvate Kinase Deficiency, the protein does not function properly and the red blood cell lives considerably shorter than normal. By testing the DNA and searching for one of these mutation(s) in the PKLR gene, the diagnosis of Pyruvate Kinase Deficiency can be confirmed. The genetic testing is done through a blood test.
“When our daughter was 9 months old, we still didn’t know what was wrong with her. The local hospital referred us to an academic hospital where they took our DNA and finally, they found out that our daughter had a rare genetic disease called ‘pyruvate kinase deficiency’ and that we were both carrier of this disease. We were relieved to know what she had, but we were sad that there was not a lot they could do about it.”
Mother of a 2 year old girl, The Netherlands
Disclaimer: This article is written by patients and is meant for basic informational purposes only. It is not intended to serve as medical advice, substitute for a doctor's appointment or to be used for diagnosing or treating a disease. Users of this website are advised to consult with their physician before making any decisions concerning their health. For details see our full disclaimer.